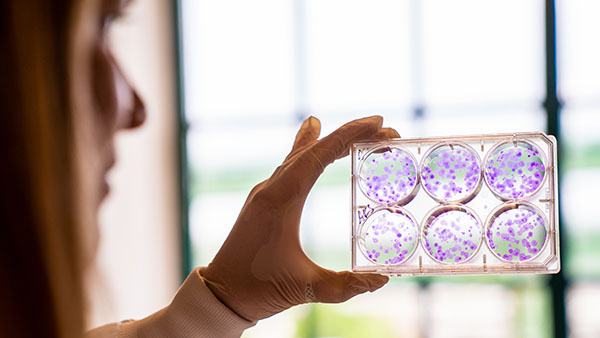
Researcher in the Corcoran lab. Researcher in the Corcoran lab.

Krantz Family
Center for Cancer Research


Advancing Cancer Research
Our mission is to conduct fundamental basic and translational research on cancer, through a highly innovative, multidisciplinary and collaborative environment. We are committed to teaching and training the next generation of cancer researchers, within a multidisciplinary collegial and collaborative research community. Through scientific innovation, we strive for global impact on the treatment, early diagnosis and prevention of all forms of cancer.
Discover Our Strengths
Learn what makes the Krantz Family Center for Cancer Research so unique.
Meet Our Investigators
We have a dedicated faculty of over 50 independent investigators using state-of-the-art tools in a variety of fields.
Support Our Mission
When you support the Krantz Family Center for Cancer Research you will help us harness the power of science and uncover new and more effective ways to fight cancer.
View Our Annual Report
Learn more about our research in our 2024 annual report (PDF is large, please be patient as it loads).


Daniel Haber, MD, PhDFundamental research really is what drives these breakthroughs in clinical care that we’ve been seeing. It’s not just happening by magic. It’s happening because there’s amazing science.
Director, Krantz Family Center for Cancer Research
Support the Krantz Family Center for Cancer Research
When you support us you are enabling discoveries that will lead to effective new weapons in the battle against cancer.
A Top Hospital in America
Mass General is recognized as a top hospital on the U.S. News Best Hospitals Honor Roll for 2024-2025.
A Leading Cancer Center Recognized for Patient Care & Research
Mass General Cancer Center is a member of the NCI-recognized DF/HCC Comprehensive Cancer Center, and National Comprehensive Cancer Network® member.
Krantz Family Center for Cancer Research
The Krantz Family Center for Cancer Research's faculty collaborate with Mass General's leading oncologists, surgeons, radiologists, pathologists and other health care professionals to advance the frontiers of cancer medicine.